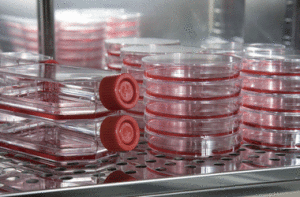
培養成功CIK細胞

CIK細胞培育
CIK細胞培育研發機構
2011年10月3日,加拿大的斯坦曼教授因其在免疫系統領域以及樹突狀細胞(即DC細胞)等一系列研究發現,獲得了2011年的諾貝爾生理學或醫學獎。斯坦曼教授是我院性病專家汪主任的導師,汪主任08年回國後潛心研究DC細胞在臨床上用於人類乳頭瘤病毒(HPV)上治療取得了可喜的效果,DC細胞像雷達一樣能主動搜尋識別(腫瘤CIK)細胞,將信息傳遞給免疫活性細胞,促進其激活和大量增殖,具有針對性的能提升免疫能力;DC細胞活性因子像飛彈一樣能精準殺死人類乳頭瘤病毒細胞,而不傷害任何正常組織,特別擅長清除殘留、微小變異頑固病毒,防止(腫瘤CIK)復發,同時提升機體免疫力。尤其對人類乳頭瘤病毒6型、11型、18型能夠識別尋找直接徹底殺滅;研究表明人類乳頭瘤病毒據不完全統計3年來治療全國各地腫瘤久治不愈、反覆發作的患者3800多例,到目前跟蹤回訪配合治療的患者無一例復發。(武警河南省總隊醫院(原解放軍764野戰醫院),始建於1964年9月,1982年9月移交武警河南總隊,1985年從河南省臨汝縣遷入現址。醫院占地96畝,固定資產2億多元,現有30個科室,展開床位700張。設有武警部隊眼科研究所、肝膽結石治療中心、脊柱外科治療中心,神經幹細胞治療中心,頸肩腰腿痛治療中心和計畫生育技術服務指導中心。)原理
主要是根據細胞與分子免疫學原理,將患者自身血中的的免疫細胞,在體外誘導產生大量能特異性識別並殺滅HPV及其感染細胞的效應細胞,將其回輸患者自身後,對HPV進行精確性、特異性、主動式攻擊,殺滅體內HPV病毒,實現了真正的個體化治療。CIK細胞是一種新的免疫活性細胞,它是自體外周血單個核細胞,經過多種細胞因子共同誘導培養產生的一類CD3+CD56+共同表達的高細胞毒性細胞(殺傷細胞),兼有T淋巴細胞強大的腫瘤殺傷活性和自然殺傷細胞(NK)的非主要組織相容性複合物(MHC)限制性殺瘤的特點,殺傷活性可達84.7%。功能介紹
治療腫瘤技術可以打破患者病部免疫抵制狀態。根據患者不同感染狀態和腫瘤(CA)類型先從患者體內提取部分單個核細胞,以特有技術賦予識別抗原的特異性,誘導患者自體免疫細胞增殖,然後再回輸到患者體內,高效靶向性殺滅血液中和細胞內的HPV病毒。
培養成功CIK細胞
培養成功CIK細胞DC細胞成熟運用
“CIK免疫細胞療法”在腫瘤治療抗復發方面的療效明確。DC細胞成熟運用於“CIK免疫細胞療法”。此療法抽取適量人體外周血通過專項GMP標準實驗室進行活化和增值,分理出DC和DC——CIK兩種細胞,然後回輸到患者體內和局部注射,從而殺死HPV細胞,提升免疫力,防止復發和轉移,安全無副作用。據了解,“CA免疫細胞療法”聯合其他療法,是國際醫學認為細胞免疫治療為(HPV)治療的唯一可以徹底殺死(HPV)細胞的治療手段。
“CIK免疫細胞療法”研究發現
樹突狀細胞(DC細胞)是已知體內功能最強、惟一能活化靜息T細胞的專職抗原提呈細胞,是啟動、調控和維持免疫應答的中心環節。它能在機體內外捕獲抗原後,將信息傳遞給T、B淋巴細胞,從而引發一系列的特異性免疫應答反應。將體外大量活化培養負載腫瘤抗原的DC細胞回輸給病人,刺激病人機體T淋巴細胞分化為具有抗腫瘤活性的細胞毒性T淋巴細胞,產生強烈的特異性抗腫瘤免疫反應。DC細胞在抵禦惡性腫瘤發揮重要作用,可以增強患者化療後的機體免疫力。2011年10月3日,加拿大的斯坦曼教授因其在免疫系統領域以及樹突狀細胞(即DC細胞)等一系列研究發現,獲得了2011年的諾貝爾生理學或醫學獎。斯坦曼教授是我院(武警河南總隊醫院)性病專家龔主任的導師,龔主任08年回國後潛心研究DC細胞在臨床上用於人類乳頭瘤病毒(HPV)上治療取得了可喜的效果,DC細胞像雷達一樣能主動搜尋識別(腫瘤CIK)細胞,將信息傳遞給免疫活性細胞,促進其激活和大量增殖,具有針對性的能提升免疫能力;DC細胞活性因子像飛彈一樣能精準殺死人類乳頭瘤病毒細胞,而不傷害任何正常組織,特別擅長清除殘留、微小變異頑固病毒,防止(腫瘤CIK)復發,同時提升機體免疫力。尤其對人類乳頭瘤病毒6型、11型、18型能夠識別尋找直接徹底殺滅;研究表明人類乳頭瘤病毒據不完全統計3年來治療全國各地腫瘤久治不愈、反覆發作的患者38000多例,到目前跟蹤回訪配合治療的患者無一例復發。“CIK免疫細胞療法”主要是根據細胞與分子免疫學原理,將患者自身的免疫細胞,在體外誘導產生大量能特異性識別並殺滅HPV及其感染細胞的效應細胞,將其回輸患者自身後,對HPV進行精確性、特異性、主動式攻擊,殺滅體內HPV病毒,實現了真正的個體化治療。“CIK免疫細胞療法”治療腫瘤技術可以打破患者病部免疫抵制狀態。根據患者不同感染狀態和腫瘤(CIK)類型先從患者體內提取部分單個核細胞,以特有技術賦予識別抗原的特異性,誘導患者自體免疫細胞增殖,然後再回輸到患者體內,高效靶向性殺滅血液中和細胞內的HPV病毒。DC細胞成熟運用:“CIK免疫細胞療法”DC細胞成熟運用於“CIK免疫細胞療法”。此療法抽取適量人體外周血通過專項GMP標準實驗室進行活化和增值,分理出DC和DC——CIK兩種細胞,然後回輸到患者體內和局部注射,從而殺死HPV細胞,提升免疫力,防止復發和轉移,安全無副作用。據了解,“CIK免疫細胞療法”聯合其他療法,是國際醫學認為細胞免疫治療為(HPV)治療的唯一可以徹底殺死(HPV)細胞的治療手段,21世紀我們將進入細胞治療的時代。”武警河南總隊醫院細胞治療移植中心,經過多年臨床實踐,針對腫瘤難治癒、易復發等特點引進【CIK免疫細胞療法】,該療法針對性強,可選擇性地殺傷腫瘤細胞和病毒感染後異常增生的細胞,對正常組織細胞無損傷。靶組織選擇性高,且能使靶組織內的濃度迅速達到最高,毒副反應小,安全性高。組分為單一化合物,而非混合物,在體內的清除時間短。同時,因其能局部治療,方法簡便,易於操作,復發率極低,可重複治療,受到患者的歡迎。
優勢
突破一:解決傳統方法不能根除的局限傳統方法大多只能在大劑量抗毒後,暫時控制症狀,卻不能徹底根除。究其原因是這些傳統藥物只從單一的表面治療入手,而真正根除腫瘤要從肌體免疫抗毒入手。採用"CIK免疫細胞療法”治療加以細胞免疫培養進行鞏固治療,是套用人體自身免疫,對病理部結構進行精確定位,將免疫細胞導入靶點進行操作,從而清除外表病毒和體內病毒,並使人體內常久對此病毒對抗免疫。突破二:解決腫瘤治療慢的難題“CIK免疫細胞療法”採用系列藥物和免疫細胞與傳統方法不同的是它是國家唯一經過超微量化配比過的藥物,其結構為微水分子並具有十分強的活性,其外層還有一層粒子膜,完全附合細胞組織環境,避免了有效成份的浪費消耗,直接到達病灶,吸收更快,更充分。
突破三:解決腫瘤復發的缺點傳統治療方法往往需要一個多月才能基本控制病情,而且還容易復發,並切容易出現耐藥性,我院(武警河南總隊醫院)採用“CIK免疫細胞療法”可以讓患者在最短的時間內達到最快最好的治療效果,一般患者的症狀數日症狀開始緩解,治療一段時間就可以完全康復。

